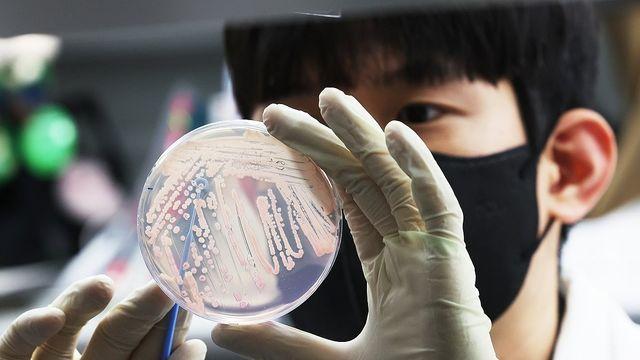
thumbimg

⚡ 뉴스 pick
- 결국 이마트까지 꺾었다…한국인이 6개월간 20조 결제한 '마트'
- 2026.04.01 [위키트리]
- 김관영 전북지사 ‘돈봉투 의혹’…경찰 수사·민주당 감찰로
- 2026.04.01 [투데이신문]
- 광운대 이희대 교수, 신간 ‘호모 인플루언서’ 출간
- 2026.04.01 [위키트리]
- 메가MGC커피, '홈플 익스프레스' 인수 참전…물류망 쥐고 '퀵커머스' 정조준
- 2026.04.01 [위키트리]
- 코트라, 美 보스턴서 '첨단산업 해외인재 유치 로드쇼'
- 2026.04.01 [연합뉴스]
- 민형배, 주철현과 단일화…전남광주통합특별시장 경선 3파전
- 2026.04.01 [아주경제]
- '고용보험 부정수급 반드시 적발한다'…기획조사·특별점검 실시
- 2026.04.01 [연합뉴스]
- 비식별 데이터로 안전하게…KISA, 120다산콜 AI 상담 고도화
- 2026.04.01 [연합뉴스]
- '정당활동 방해도 테러' 개정안에 인권위 "기본권 침해 우려"
- 2026.04.01 [연합뉴스]
- 인권위 "6세 이하 수영장 출입금지 양양군, 개선권고 안 따라"
- 2026.04.01 [연합뉴스]
- 설명절에 2월 온라인 쇼핑 역대 최대…농축수산물·음식료품↑
- 2026.04.01 [연합뉴스]
- 2026년 4월호 VOL1 마리끌레르 코리아 편집장의 에디터스 레터
- 2026.04.01 [마리끌레르]
- 금감원, 보이스피싱 사기범 목소리 공개…"일단 전화 끊어야"
- 2026.04.01 [연합뉴스]
- 농식품부, 동계 전략작물직불금 신청 24일까지 연장
- 2026.04.01 [연합뉴스]
- '李대통령 허위사실 유포' 전한길, 3차 소환…"날 겁주는 건가"
- 2026.04.01 [이데일리]
- 트럼프, 내일 대국민 연설서 종전 선언 하나…美, 지상군 집결·이란 미군기지 공격 '긴장 여전'
- 2026.04.01 [폴리뉴스]
- KIEP "중동산 원유 비중 3년째 70%…호주·앙골라 활용해야"
- 2026.04.01 [연합뉴스]
- 이 대통령, 인도네시아 대통령과 오늘(1일) 정상회담…'무궁화대훈장' 수여
- 2026.04.01 [위키트리]
- 라면에 넣은 산나물 먹고 '마비·구토'…6명 병원행(종합2보)
- 2026.04.01 [연합뉴스]
- 고사리 삶을 땐 '이것' 꼭 넣어보세요… 고급 한정식 식당에서만 쓰는 '방법'입니다
- 2026.04.01 [위키푸디]